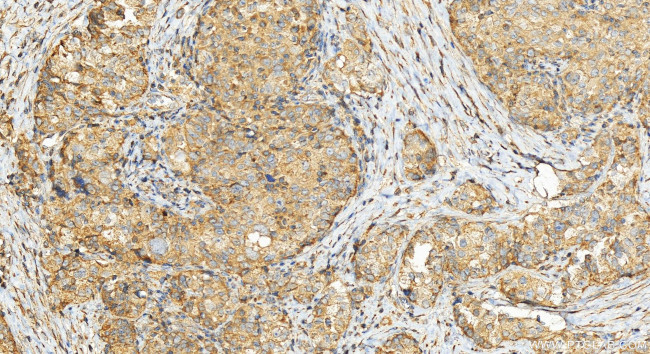
CBARA1 Antibody in Immunohistochemistry (Paraffin) (IHC (P))

Search
Proteintech
CBARA1 Polyclonal Antibody
{{$productOrderCtrl.translations['antibody.pdp.commerceCard.promotion.promotions']}}
{{$productOrderCtrl.translations['antibody.pdp.commerceCard.promotion.viewpromo']}}
{{$productOrderCtrl.translations['antibody.pdp.commerceCard.promotion.promocode']}}: {{promo.promoCode}} {{promo.promoTitle}} {{promo.promoDescription}}. {{$productOrderCtrl.translations['antibody.pdp.commerceCard.promotion.learnmore']}}
产品信息
25905-1-AP
种属反应
宿主/亚型
分类
类型
抗原
偶联物
形式
浓度
规格
纯化类型
保存液
内含物
保存条件
运输条件
产品详细信息
Immunogen sequence: KMFDLNGDGE VDMEEFEQVQ SIIRSQTSMG MRHRDRPTTG NTLKSGLCSA LTTYFFGADL KGKLTIKNFL EFQRKLQHDV LKLEFERHDP VDGRITERQF GGMLLAYSGV QSKKLTAMQR QLKKHFKEGK GLTFQEVENF FTFLKNINDV DTALSFYHMA GASLDKVTMQ QVARTVAKVE LSDHVCDVVF ALFDCDGNGE LSNKEFVSIM KQRLMRGLEK PKDMGFTRLM QAMWKCAQET AWDFALPKQ
靶标信息
MICU1 is a key regulator of mitochondrial calcium uptake required for calcium entry into mitochondrion. It may act as a calcium sensor via its EF-hand domains, gating the activity of a calcium channel partner. MICU1 induces T-helper 1-mediated autoreactivity, which is accompanied by the release of IFNG.
仅用于科研。不用于诊断过程。未经明确授权不得转售。
篇参考文献 (0)
生物信息学
蛋白别名: ara CALC; Atopy-related autoantigen CALC; calcium binding atopy-related autoantigen 1; Calcium uptake protein 1, mitochondrial; Calcium-binding atopy-related autoantigen 1; Calcium-binding atopy-related autoantigen 1 homolog; DKFZp564C246; FLJ12684; unnamed protein product
基因别名: ara CALC; C730016L05Rik; CALC; CBARA1; EFHA3; MICU1; MPXPS
UniProt ID: (Human) Q9BPX6, (Mouse) Q8VCX5, (Rat) Q6P6Q9
Entrez Gene ID: (Human) 10367, (Mouse) 216001, (Rat) 365567